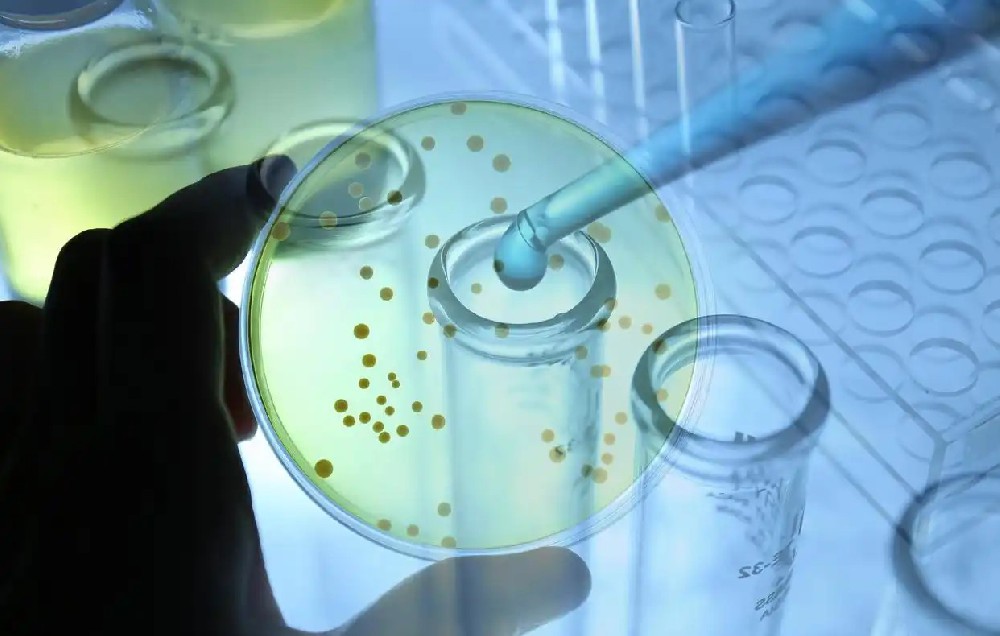

細胞轉染作為基因功能研究和生物技術應用的核心實驗,其成功高度依賴精準的液體處理。博清生物科技(南京)有限公司研發的單道移液器憑借高精度設計、人體工程學優化及創新技術,顯著提升了細胞轉染實驗的準確性、效率及重復性。
細胞轉染是將外源核酸(如質粒DNA、siRNA或mRNA)導入真核細胞的過程,是研究基因表達、蛋白質功能、信號通路及疾病機制的基石技術。成功的轉染需嚴格控制試劑比例、移液精度及操作規范性,而微量移液器作為核心工具,其性能直接影響實驗結果的可靠性。傳統移液器在長期操作中易因精度漂移、重復性差或人體工學缺陷導致誤差,尤其在處理納米級轉染復合物(如脂質體-DNA復合物)或高價值微量樣品時更為顯著。博清生物科技(南京)有限公司研發的單道移液器通過精密設計與技術創新,有效解決了這些痛點,為細胞轉染提供了可靠保障。
一、細胞轉染的挑戰與移液技術的關鍵作用
(一)細胞轉染的成功依賴多個環節的精準控制:
1、細胞狀態:貼壁細胞需處于對數生長期(匯合度70–90%),懸浮細胞需密度均一且活性高;
2、試劑配制:轉染試劑(如脂質體、PEI)與核酸需按精確比例混合,形成穩定復合物,比例偏差或操作不當易導致低效率或細胞毒性;
3、復合物穩定性:混合后孵育時間、移液沖擊等因素影響復合物粒徑與轉染效率;
4、接種精度:復合物添加至細胞時需避免局部濃度過高或機械損傷。
(二)傳統移液器的常見問題包括:
1、精度誤差:量程調節不準確或活塞密封老化導致體積偏差,尤其在低量程(如0.1–10μL)時影響顯著;
2、交叉污染風險:吸頭安裝不緊密或殘留液滴污染后續樣品;
3、操作疲勞:長時間移液導致手部勞損,影響重復性;
4、溫度效應:手心溫度傳遞至移液器主體導致液體體積變化(熱脹冷縮)。
二、移液器在細胞轉染實驗中的具體應用
博清移液器貫穿細胞轉染全流程,顯著提升各環節效率與質量:
(一)細胞準備階段:
使用1–5mL量程移液器精準更換培養基、胰酶消化細胞或重懸細胞,確保細胞密度均一(如懸浮細胞計數后稀釋至2–4×10?cells/mL)。
(二)轉染試劑配制:
1、稀釋核酸與試劑:采用0.1–20μL量程移液器,精確量取DNA/RNA溶液和轉染試劑;
2、復合物混合:輕柔移液混合避免劇烈震蕩,確保復合物粒徑均一。博清移液器的低阻力活塞允許緩慢、可控的吹吸操作,減少剪切力對復合物的破壞;
3、室溫孵育控制:按方案準確計時后,用同一移液器轉移復合物至細胞,避免多工具交叉污染。
(三)接種與培養階段:
將復合物以逐滴方式均勻加入培養孔邊緣,避免直接沖擊細胞層。博清移液器的精準排液(雙檔按鈕設計,第一檔排出大部分液體,第二檔排空殘留)確保無滴液殘留,減少孔間差異。
換液與觀察:轉染后更換培養基時,使用大口徑吸頭(如5mL量程)輕柔移除上清,避免擾動貼壁細胞或復合物吸附層。
博清生物科技(南京)有限公司研發的單道移液器通過高精度機械設計、人體工學優化及防污染創新,顯著提升了細胞轉染實驗的效率、準確性和重復性。其在試劑配制、復合物混合及細胞接種等關鍵環節的精準控制,有效減少了人為誤差,保障了轉染效率與細胞活性,為基因功能研究、藥物篩選及細胞治療等領域提供了可靠工具支撐。未來,結合自動化移液工作站或智能數據記錄系統,博清移液器有望進一步整合至高通量轉染平臺,推動細胞生物學研究的標準化與規模化發展。
博清生物科技(南京)有限公司研發的單道移液器的應用不僅局限于細胞轉染,其在PCR體系構建、蛋白質純化、ELISA等生命科學實驗中同樣展現卓越性能,成為實驗室精密液體處理的核心工具之一。





